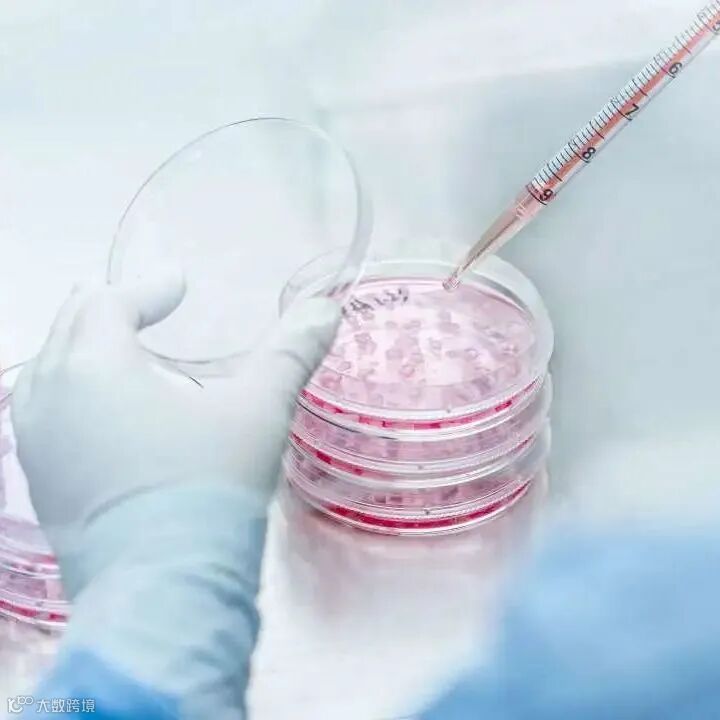

2023年广州市黄埔区 广州开发区
提升全民科学素质 助力科技自立自强


2023年9月19日
2023年广州市黄埔 广州开发区
全国科普日活动正式拉开帷幕
瑞因科普志愿服务队
走进校园
为孩子们带去有趣有料的
生命科学趣味科普知识
带青少年走进生物科技的奇妙世界




瑞因生命科学科普研学教育基地作为大开“研”界,科“创”未来2023年黄埔少年科学院思政科普研学活动支持单位,在2023年广州市黄埔 广州开发区全国科普日活动开幕式上获广州市黄埔区教育局、广州市黄埔区科学技术协会 广州开发区科学技术协会授予荣誉证书。




全国科普日~黄埔军校中学

瑞因科普志愿者以基因、细胞、微生物科普绘本为载体,以有奖问答的形式,融入DNA双螺旋模型动手体验的互动环节,和孩子们科普分享生命科学科普知识。现场黄埔军校中学的学生们积极热情参与各项科普互动环节,发挥团队协作的力量,成功完成一个个DNA双螺旋模型的搭建,并带着模型向同学们分享参与体验感受。










全国科普日~开发区中学

2023年广州市黄埔区 广州开发区全国科普日活动,瑞因科普志愿者团队第二站走进开发区中学。活动现场,可爱的学生们和瑞因科普志愿者上演了一场紧张刺激的生命科学科普竞赛,生命科学科普问答积分赛制激起了孩子们的求知欲,激发了孩子们对生命科学的兴趣,现场孩子们还现场互问互答,就课堂上学到的生物知识展开了紧张又有趣的交流讨论,现场氛围兼具热烈与趣味性。瑞因科普志愿者团队也为每一位积极参与科普互动的同学们送上了瑞因科普基地专属IP钥匙扣和徽章,鼓励孩子们积极主动提升科学素养,探索更多的科学世界。






瑞因科普将始终坚持
打造专业、负责、优质的
科普志愿服务团队
为每一位青少年提供
生命科学的学习土壤
在青少年心中播下科学的种子
激发青少年的科学好奇心
想象力、探索欲
培育具备科学家潜质
愿意献身科学研究事业的青少年群体